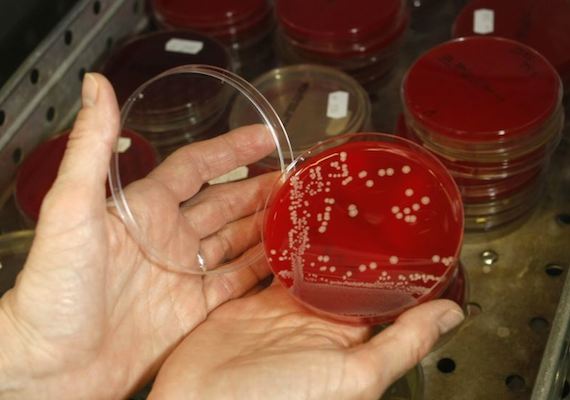

Doctors have identified a powerful bacteria that cannot be killed with antibiotics. The bacteria, called a superbug, was found in a woman from Pennsylvania. Tom Frieden is the head of the U.S. Centers for Disease Control and Prevention. He says this new bug is resistant to every antibiotic available, including colistin. Colistin is used only as a last measure, as the drug can cause organ damage. The woman is infected with a rare kind of E. coli bacteria known as CRE. The version she has includes a gene that is resistant to colistin. This is its first appearance in the United States. Researchers who studied the case in Pennsylvania wrote about their findings in Antimicrobial Agents and Chemotherapy, a publication of the American Society for Microbiology. They wrote that the case could signal the development of “a truly pan-drug resistant bacteria.” Health officials consider CRE, “nightmare bacteria.” They can kill up to 50 percent of infected patients.
Title: This Superbug Is Too Strong for Antibiotics
Content: <div id='article-page'><div id='article-content' data-media-url='//news-app-staging.s3.amazonaws.com' data-base-url='//news-app-staging.herokuapp.com' data-sound-name='https://news-app-production.s3.amazonaws.com/articles/1096/super_audio.m4a' data-capture-url='//staging.analytics.lingraphica.com/events/capture_news' data-article-title='This Superbug Is Too Strong for Antibiotics' data-article-id='1586'><script src='//news-app-staging.herokuapp.com/javascripts/getscripts.js'></script><link rel='stylesheet' href='//news-app-staging.herokuapp.com/stylesheets/article.css' type='text/css' /><div class='article'><p><span data-start-time='0' data-end-time='6979'>Doctors have identified a powerful bacteria that cannot be killed with antibiotics.</span> <span data-start-time='6979' data-end-time='13646'>The bacteria, called a superbug, was found in a woman from Pennsylvania.</span> <span data-start-time='13646' data-end-time='20833'>Tom Frieden is the head of the U.S. Centers for Disease Control and Prevention.</span> <span data-start-time='20833' data-end-time='29063'>He says this new bug is resistant to every antibiotic available, including colistin.</span> <span data-start-time='29063' data-end-time='36000'>Colistin is used only as a last measure, as the drug can cause organ damage.</span> <span data-start-time='36000' data-end-time='44063'>The woman is infected with a rare kind of E. coli bacteria known as CRE.</span> <span data-start-time='44063' data-end-time='50458'>The version she has includes a gene that is resistant to colistin.</span> <span data-start-time='50458' data-end-time='54854'>This is its first appearance in the United States.</span> <span data-start-time='54854' data-end-time='69417'>Researchers who studied the case in Pennsylvania wrote about their findings in Antimicrobial Agents and Chemotherapy, a publication of the American Society for Microbiology.</span> <span data-start-time='69417' data-end-time='77792'>They wrote that the case could signal the development of “a truly pan-drug resistant bacteria.”</span> <span data-start-time='77792' data-end-time='83042'>Health officials consider CRE, “nightmare bacteria.”</span> <span data-start-time='83042' data-end-time='87542'>They can kill up to 50 percent of infected patients.</span> </p></div><div class='control-buttons-sticky' style='display:none;'><div class='control-buttons'><button title='Back' class='back' disabled='disabled'></button><button title='Play' class='play' disabled='disabled'></button><button title='Pause' class='pause' style='display:none;'></button><button title='Forward' class='forward' disabled='disabled'></button><button class='finished-reading' style='display:none;'>Done</button></div></div></div><div id='article-media'><div id='media-image'><img src='https://news-app-production.s3.amazonaws.com/articles/1096/super_img.jpg'/></div></div><div id='question-content' style='display:none;'><div class='vocabulary_question question-container' data-question-id=6334 data-hint-location='77792' style='display:none;'><div class='question' data-sound-name='https://news-app-production.s3.amazonaws.com/articles/1096/what_does_nightmare_mean.m4a'>What does nightmare mean?</div><div class='choices' data-correct-choice='a very bad dream'><div class='choice' data-sound-name='https://news-app-production.s3.amazonaws.com/articles/1096/a_very_bad_dream.m4a'><span>a very bad dream</span></div><div class='choice' data-sound-name='https://news-app-production.s3.amazonaws.com/articles/1096/an_antibiotic.m4a'><span>an antibiotic</span></div><div class='choice' data-sound-name='https://news-app-production.s3.amazonaws.com/articles/1096/responsible_for_something.m4a'><span>responsible for something</span></div><div class='choice' data-sound-name='https://news-app-production.s3.amazonaws.com/articles/1096/a_cure_that_is_very_effective.m4a'><span>a cure that is very effective</span></div></div></div><div class='multiple_choice_question question-container' data-question-id=6335 data-hint-location='0' style='display:none;'><div class='question' data-sound-name='https://news-app-production.s3.amazonaws.com/articles/1096/what_is_the_bacteria_resistant_to.m4a'>What is the bacteria resistant to?</div><div class='choices' data-correct-choice='antibiotics'><div class='choice' data-sound-name='https://news-app-production.s3.amazonaws.com/articles/1096/poison.m4a'><span>poison</span></div><div class='choice' data-sound-name='https://news-app-production.s3.amazonaws.com/articles/1096/sanitizer.m4a'><span>sanitizer</span></div><div class='choice' data-sound-name='https://news-app-production.s3.amazonaws.com/articles/1096/antibiotics.m4a'><span>antibiotics</span></div><div class='choice' data-sound-name='https://news-app-production.s3.amazonaws.com/articles/1096/shots.m4a'><span>shots</span></div></div></div><div class='sentence_completion_question question-container' data-question-id=6336 data-hint-location='50458' style='display:none;'><div class='question' data-sound-name='https://news-app-production.s3.amazonaws.com/articles/1096/this_is_the_first__blank__of_cre_in_the_us.m4a'>This is the first <span class='blank'>appearance</span> of CRE in the U.S.</div><div class='choices' data-correct-choice='appearance'><div class='choice' data-sound-name='https://news-app-production.s3.amazonaws.com/articles/1096/death.m4a'><span>death</span></div><div class='choice' data-sound-name='https://news-app-production.s3.amazonaws.com/articles/1096/appearance.m4a'><span>appearance</span></div><div class='choice' data-sound-name='https://news-app-production.s3.amazonaws.com/articles/1096/treatment.m4a'><span>treatment</span></div><div class='choice' data-sound-name='https://news-app-production.s3.amazonaws.com/articles/1096/survival.m4a'><span>survival</span></div></div></div><div class='question-buttons'><button class='skip-button'></button><button class='hint-button'></button><button class='speak-button'></button></div></div></div>
Sound Name: https://news-app-production.s3.amazonaws.com/articles/1096/super_audio.m4a
Preview